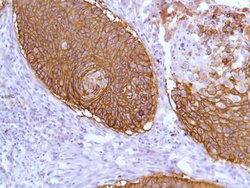
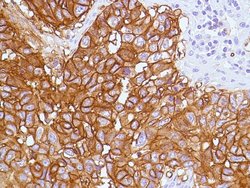

Antibody data
- Antibody Data
- Antigen structure
- References [0]
- Comments [0]
- Validations
- Immunohistochemistry [11]
Submit
Validation data
Reference
Comment
Report error
- Product number
- ABIN1687567 - Provider product page

- Provider
- antibodies-online
- Product name
- anti-Solute Carrier Family 2 (Facilitated Glucose Transporter), Member 1 (SLC2A1) antibody
- Antibody type
- Monoclonal
- Antigen
- Other
- Reactivity
- Human
- Host
- Mouse
- Antibody clone number
- SPM498
- Vial size
- 0.5 mL
- Storage
- 4°C
No comments: Submit comment
Supportive validation
- Submitted by
- antibodies-online (provider)
- Main image

- Experimental details
- Image(s): Immunohistochemistry
- Submitted by
- antibodies-online (provider)
- Main image

- Experimental details
- Image(s): Immunohistochemistry
- Submitted by
- antibodies-online (provider)
- Main image

- Experimental details
- Image(s): Immunohistochemistry
- Submitted by
- antibodies-online (provider)
- Main image

- Experimental details
- Image(s): Immunohistochemistry
- Submitted by
- antibodies-online (provider)
- Main image

- Experimental details
- Image(s): Immunohistochemistry
- Submitted by
- antibodies-online (provider)
- Main image

- Experimental details
- Image(s): Immunohistochemistry
- Submitted by
- antibodies-online (provider)
- Main image

- Experimental details
- Image(s): Immunohistochemistry
- Submitted by
- antibodies-online (provider)
- Main image
- Experimental details
- Image(s): Immunohistochemistry
- Submitted by
- antibodies-online (provider)
- Main image

- Experimental details
- Image(s): Immunohistochemistry
- Submitted by
- antibodies-online (provider)
- Main image
- Experimental details
- Image(s): Immunohistochemistry
- Submitted by
- antibodies-online (provider)
- Main image

- Experimental details
- Image(s): Immunohistochemistry
 Explore
Explore Validate
Validate Learn
Learn Immunohistochemistry
Immunohistochemistry